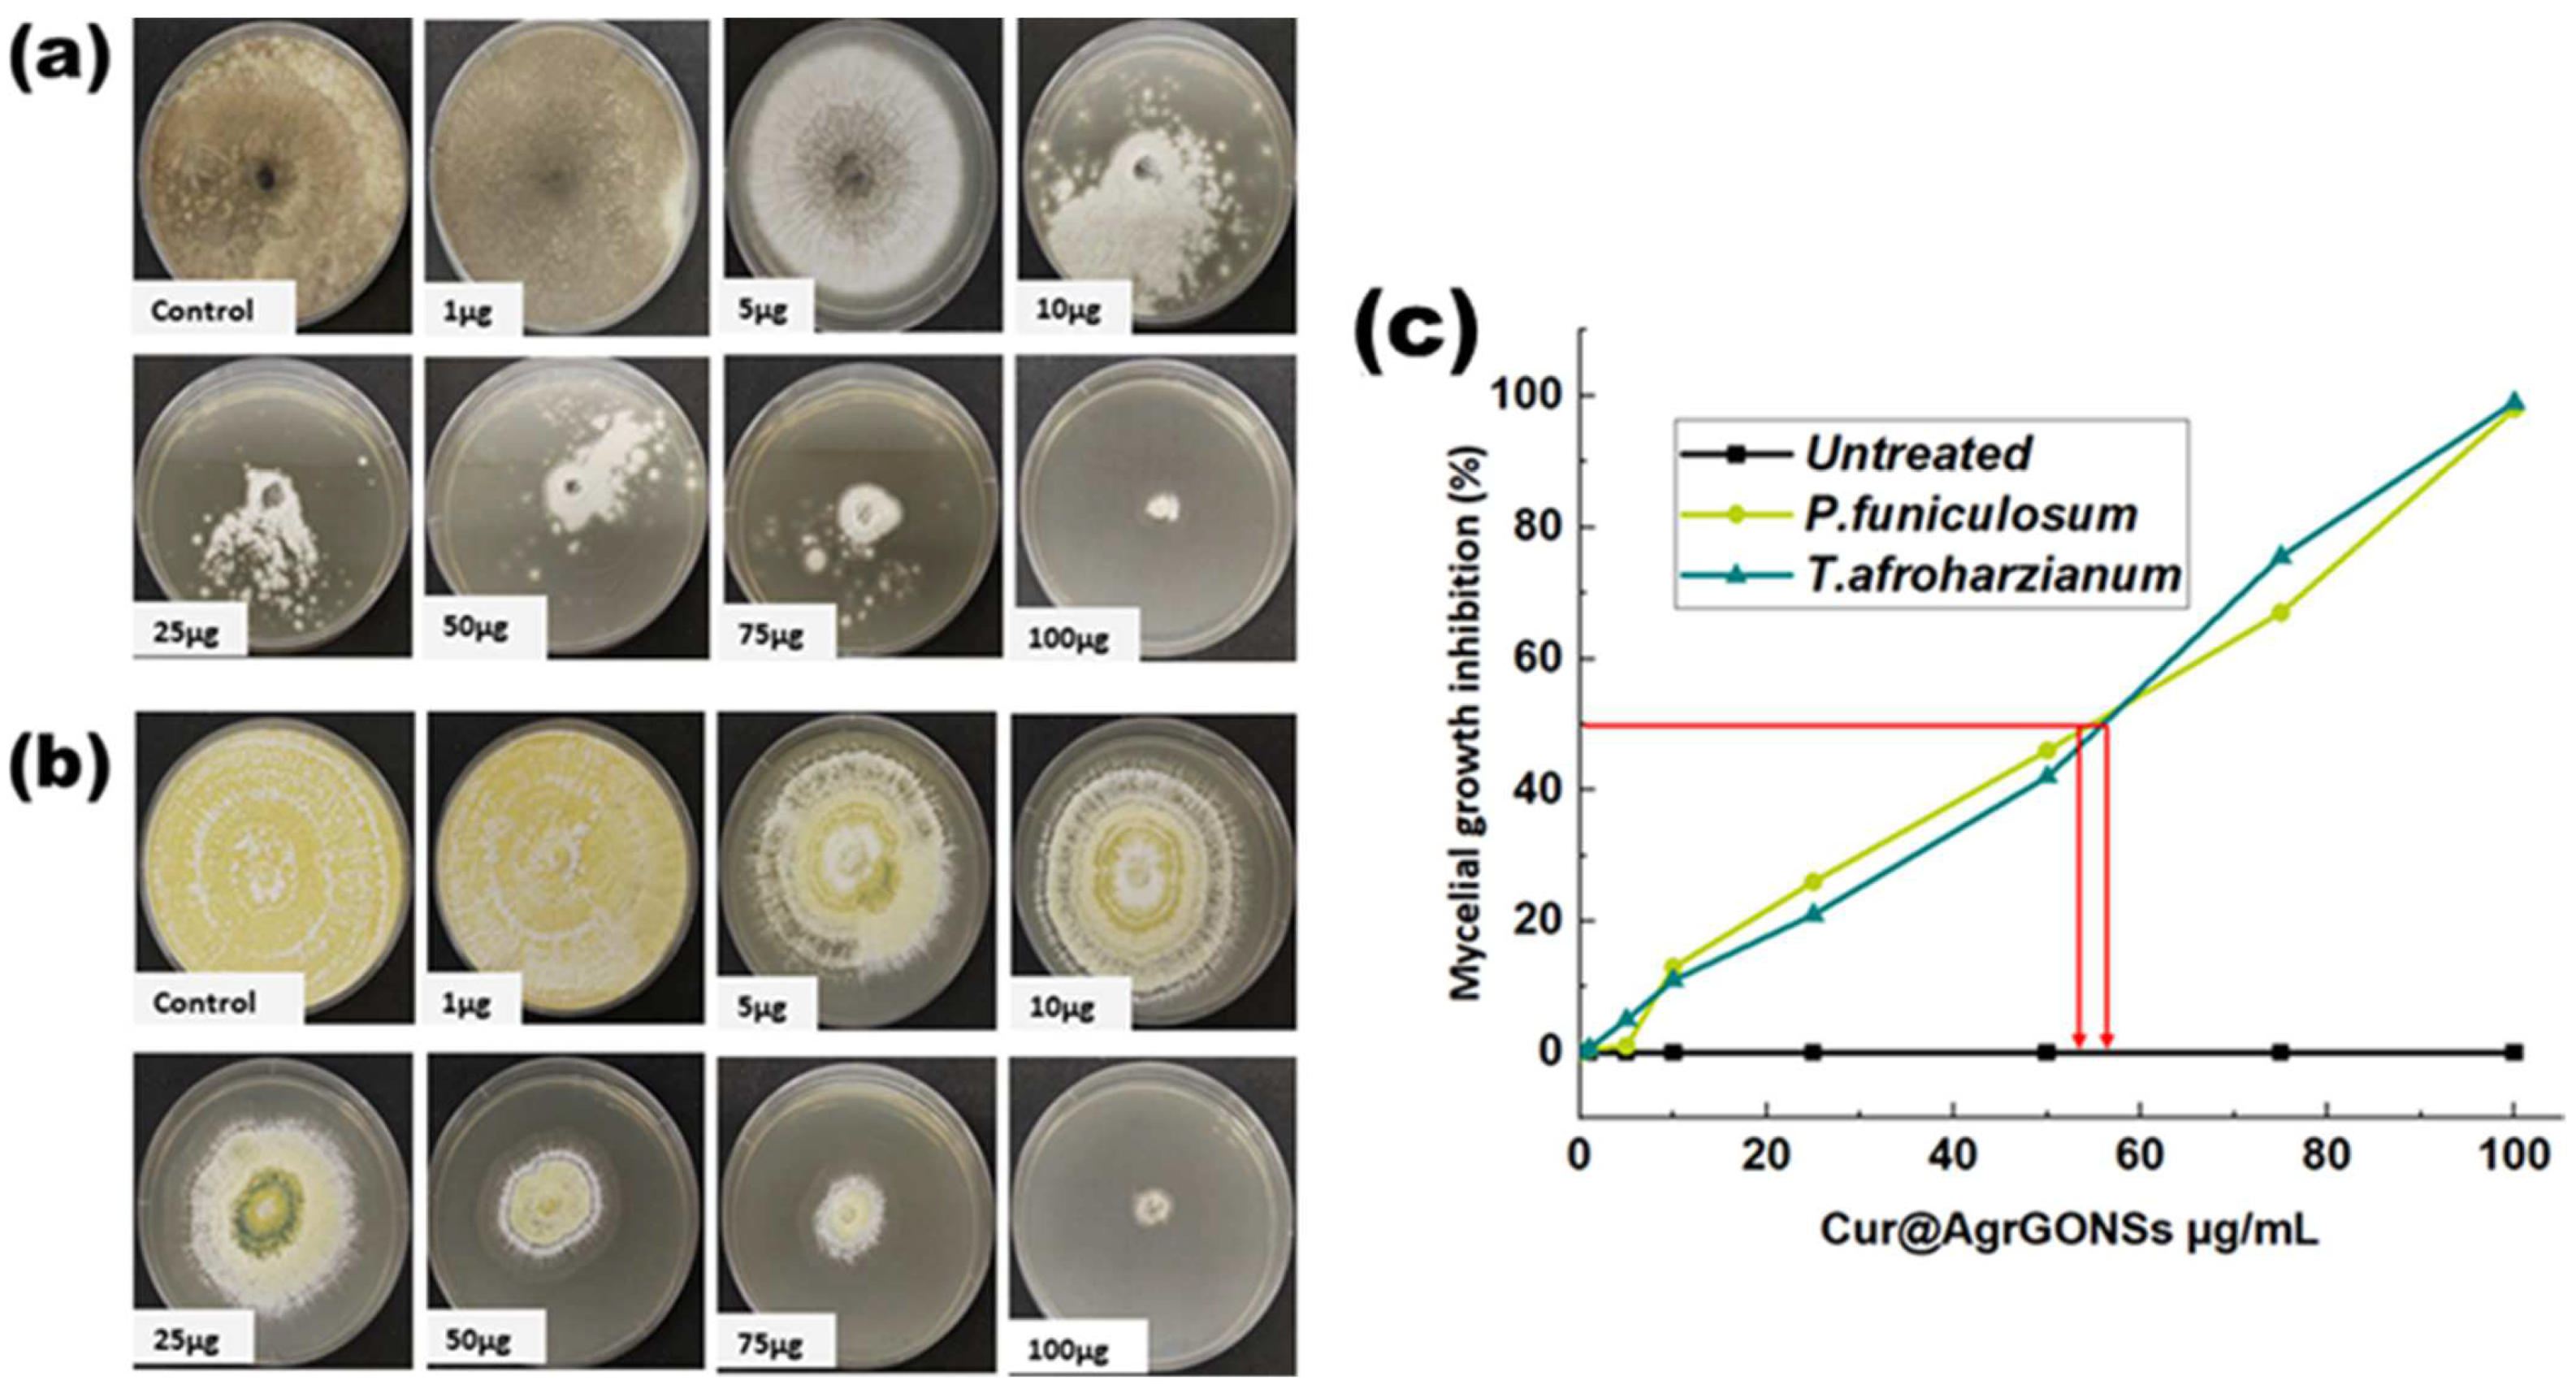
Coatings 12 00980 g008 Coatings 12 00980 g008

Surface Functionalization of Bamboo with Silver-Reduced Graphene Oxide Nanosheets to Improve Hydrophobicity and Mold Resistance
Abstract
1. Introduction
2. Materials and Methods
2.1. Isolation and Identification of Bamboo-Decaying Fungi
2.2. Graphene Oxide (GO) Synthesis
2.3. Preparation of Cur-AgrGO Nanosheets
2.4. Preparation of Cur-AgrGONSs-Impregnated Mold-Resistant Bamboo Samples
2.5. Characterization of Cur-AgrGO Nanosheets
2.6. Mold-Resistant Test
2.7. Moisture Content Evaluation by Water Absorption Test
2.8. Water Contact Angle (WCA) Test
2.9. In Vitro Decay Test
2.10. Antifungal Activity
3. Results and Discussion
3.1. Bamboo Decaying Fungi Isolation and Molecular Characterization
3.2. Preparation of Graphene Oxide and Cur-AgrGONSs
3.3. Hybridization of Bamboo with Cur-AgrGONSs
3.4. Characterization of Synthesized Cur-AgrGONSs
3.5. Mold Resistant Test
3.6. Evaluation of Moisture Content and Water Contact Angle by Water Absorption Test
3.7. In Vitro Bamboo Decay Test
3.8. Antifungal Activity
4. Conclusions
Author Contributions
Funding
Institutional Review Board Statement
Informed Consent Statement
Data Availability Statement
Acknowledgments
Conflicts of Interest
References
- Wahab, R.; Sudin, M.; Samsi, H.W. Fungal Colonisation and Decay in Tropical Bamboo Species. Appl. Sci. 2005, 5, 897–902. [Google Scholar] [CrossRef][Green Version]
- Scurlock, J.M.; Dayton, D.C.; Hames, B. Bamboo: An overlooked biomass resource. Biomass Bioenergy 2000, 19, 229–244. [Google Scholar] [CrossRef]
- Song, W.; Zhang, K.; Chen, Z.; Hong, G.; Lin, J.; Hao, C.; Zhang, S. Effect of xylanase–laccase synergistic pretreatment on physical–mechanical properties of environment-friendly self-bonded bamboo particleboards. J. Polym. Environ. 2018, 26, 4019–4033. [Google Scholar] [CrossRef]
- Jain, S.; Kumar, R.; Jindal, U.C. Mechanical behaviour of bamboo and bamboo composite. J. Mater. Sci. 1992, 27, 4598–4604. [Google Scholar] [CrossRef]
- Gugnani, H.C.; Paliwal-Joshi, A.; Rahman, H.; Padhye, A.A.; Singh, T.S.K.; Das, T.K.; Khanal, B.; Bajaj, R.; Rao, S.; Chukhani, R. Occurrence of pathogenic fungi in soil of burrows of rats and of other sites in bamboo plantations in India and Nepal. Mycoses 2007, 50, 507–511. [Google Scholar] [CrossRef]
- Hamed, S.A.M. In vitro studies on wood degradation in soil by soft-rot fungi: Aspergillus niger and Penicillium chrysogenum. Int. Biodeterior. Biodegrad. 2013, 78, 98–102. [Google Scholar] [CrossRef]
- Wu, H.; Yang, X.; Rao, J.; Zhang, Y.; Sun, F. Improvement of bamboo properties via in situ construction of polyhydroxyethyl methylacrylate and polymethyl methylacrylate networks. Bioresources 2018, 13, 6–14. [Google Scholar] [CrossRef]
- Fei, P.; Xiong, H.; Cai, J.; Liu, C.; Yu, Y. Enhanced the weatherability of bamboo fiber-based outdoor building decoration materials by rutile nano-TiO2. Constr. Build. Mater. 2016, 114, 307–316. [Google Scholar] [CrossRef]
- Agnihotri, S.; Mukherji, S.; Mukherji, S. Size-controlled silver nanoparticles synthesized over the range 5–100 nm using the same protocol and their antibacterial efficacy. RSC Adv. 2014, 4, 3974–3983. [Google Scholar] [CrossRef]
- Sarmast, M.K.; Salehi, H. Silver nanoparticles: An influential element in plant nanobiotechnology. Mol. Biotechnol. 2016, 58, 441–449. [Google Scholar] [CrossRef]
- Chang, S.T.; Yeh, T.F. Protection and fastness of green color of moso bamboo (Phyllostachys pubescens Mazel) treated with chromium-based reagents. J. Wood Sci. 2001, 47, 228–232. [Google Scholar] [CrossRef]
- Chang, S.T.; Wu, J.H. Green-color conservation of ma bamboo (Dendrocalamus latiflorus) treated with chromium-based reagents. J. Wood Sci. 2000, 46, 40–44. [Google Scholar] [CrossRef]
- Yu, Y.; Jiang, Z.; Wang, G.; Tian, G.; Wang, H.; Song, Y. Surface functionalization of bamboo with nanostructured ZnO. Wood Sci. Technol. 2012, 46, 781–790. [Google Scholar] [CrossRef]
- Marcano, D.C.; Kosynkin, D.V.; Berlin, J.M.; Sinitskii, A.; Sun, Z.; Slesarev, A.; Alemany, L.B.; Lu, W.; Tour, J.M. Improved synthesis of graphene oxide. ACS Nano 2010, 4, 4806–4814. [Google Scholar] [CrossRef]
- Mosselhy, D.A.; Abd El-Aziz, M.; Hanna, M.; Ahmed, M.A.; Husien, M.M.; Feng, Q. Comparative synthesis and antimicrobial action of silver nanoparticles and silver nitrate. J. Nanopart. Res. 2015, 17, 473. [Google Scholar] [CrossRef]
- Liu, S.; Zeng, T.H.; Hofmann, M.; Burcombe, E.; Wei, J.; Jiang, R.; Kong, J.; Chen, Y. Antibacterial activity of graphite, graphite oxide, graphene oxide, and reduced graphene oxide: Membrane and oxidative stress. ACS Nano 2011, 5, 6971–6980. [Google Scholar] [CrossRef]
- Shao, W.; Liu, X.; Min, H.; Dong, G.; Feng, Q.; Zuo, S. Preparation, characterization, and antibacterial activity of silver nanoparticle-decorated graphene oxide nanocomposite. ACS Appl. Mater. Interfaces 2015, 7, 6966–6973. [Google Scholar] [CrossRef]
- Li, C.; Wang, X.; Chen, F.; Zhang, C.; Zhi, X.; Wang, K.; Cui, D. The antifungal activity of graphene oxide–silver nanocomposites. Biomaterials 2013, 34, 3882–3890. [Google Scholar] [CrossRef]
- Tang, J.; Chen, Q.; Xu, L.; Zhang, S.; Feng, L.; Cheng, L.; Xu, H.; Liu, Z.; Peng, R. Graphene oxide–silver nanocomposite as a highly effective antibacterial agent with species-specific mechanisms. ACS Appl. Mater. Interfaces 2013, 5, 3867–3874. [Google Scholar] [CrossRef]
- Kim, S.W.; Jung, J.H.; Lamsal, K.; Kim, Y.S.; Min, J.S.; Lee, Y.S. Antifungal effects of silver nanoparticles (AgNPs) against various plant pathogenic fungi. Mycobiology 2012, 40, 53–58. [Google Scholar] [CrossRef]
- Palmieri, V.; Bugli, F.; Cacaci, M.; Perini, G.; Maio, F.D.; Delogu, G.; Torelli, R.; Conti, C.; Sanguinetti, M.; Spirito, M.D.; et al. Graphene oxide coatings prevent Candida albicans biofilm formation with a controlled release of curcumin-loaded nanocomposites. Nanomedicine 2018, 13, 2867–2879. [Google Scholar] [CrossRef]
- Kim, S.W.; Kim, K.S.; Lamsal, K.; Kim, Y.J.; Kim, S.B.; Jung, M.; Sim, S.J.; Kim, H.S.; Chang, S.J.; Kim, J.K.; et al. An in vitro study of the antifungal effect of silver nanoparticles on oak wilt pathogen Raffaelea sp. J. Microbiol. Biotechnol. 2009, 19, 760–764. [Google Scholar] [CrossRef] [PubMed]
- Yilmaz, A.; Bozkurt, F.; Cicek, P.K.; Dertli, E.; Durak, M.Z.; Yilmaz, M.T. A novel antifungal surface-coating application to limit postharvest decay on coated apples: Molecular, thermal and morphological properties of electrospun zein–nanofiber mats loaded with curcumin. Innov. Food Sci. Emerg. Technol. 2016, 37, 74–83. [Google Scholar] [CrossRef]
- Casado-Sanz, M.M.; Silva-Castro, I.; Ponce-Herrero, L.; Martín-Ramos, P.; Martín-Gil, J.; Acuña-Rello, L. White-rot fungi control on Populus spp. wood by pressure treatments with silver nanoparticles, chitosan oligomers and propolis. Forests 2019, 10, 885. [Google Scholar] [CrossRef]
- Akhtari, M.; Arefkhani, M. Study of microscopy properties of wood impregnated with nanoparticles during exposed to white-rot fungus. Agric. Sci. Dev. 2013, 2, 116–119. [Google Scholar]
- Shen, J.; Shi, M.; Yan, B.; Ma, H.; Li, N.; Ye, M. One-pot hydrothermal synthesis of Ag-reduced graphene oxide composite with ionic liquid. J. Mater. Chem. 2011, 21, 7795–7801. [Google Scholar] [CrossRef]
- Wang, J.; Sun, Q.; Sun, F.; Zhang, Q.; Jin, C. Layer-by-layer self-assembly of reduced graphene oxide on bamboo timber surface with improved decay resistance. Eur. J. Wood Wood Prod. 2018, 76, 1223–1231. [Google Scholar] [CrossRef]
- Ferreira, F.D.; Mossini, S.A.G.; Ferreira, F.M.D.; Arrotéia, C.C.; da Costa, C.L.; Nakamura, C.V.; Machinski Junior, M. The inhibitory effects of Curcuma longa L. essential oil and curcumin on Aspergillus flavus link growth and morphology. Sci. World J. 2013, 2013, 343804. [Google Scholar] [CrossRef]
- Abidin, Z.H.Z.; Naziron, N.N.; Nasir, K.M.; Rusli, M.S.; Lee, S.V.; Kufian, M.Z.; Majid, S.R.; Vengadaesvaran, B.; Arof, A.K.; Taha, R.M.; et al. Influence of curcumin natural dye colorant with PMMA-acrylic polyol blended polymer. Pigment. Resin Technol. 2013, 42, 95–102. [Google Scholar] [CrossRef]
- Necolau, M.I.; Pandele, A.M. Recent advances in graphene oxide-based anticorrosive coatings: An overview. Coatings 2020, 10, 1149. [Google Scholar] [CrossRef]
- Wang, Y.; Li, Y.; Xue, S.; Zhu, W.; Wang, X.; Huang, P.; Fu, S. Superstrong, lightweight, and exceptional environmentally stable SiO2@GO/bamboo composites. ACS Appl. Mater. Interfaces 2022, 14, 11–20. [Google Scholar] [CrossRef] [PubMed]
- Li, J.; Ren, D.; Wu, Z.; Huang, C.; Yang, H.; Chen, Y.; Yu, H. Visible-light-mediated antifungal bamboo based on Fe-doped TiO 2 thin films. RSC Adv. 2017, 7, 55131–55140. [Google Scholar] [CrossRef]
- Liu, G.; Lu, Z.; Zhu, X.; Du, X.; Hu, J.; Chang, S.; Li, X.; Liu, Y. Facile in-situ growth of Ag/TiO2 nanoparticles on polydopamine modified bamboo with excellent mildew-proofing. Sci. Rep. 2019, 9, 16496. [Google Scholar] [CrossRef] [PubMed]
- Li, J.; Su, M.; Wang, A.; Wu, Z.; Chen, Y.; Qin, D.; Jiang, Z. In situ formation of Ag nanoparticles in mesoporous TiO2 films decorated on bamboo via self-sacrificing reduction to synthesize nanocomposites with efficient antifungal activity. Int. J. Mol. Sci. 2019, 20, 5497. [Google Scholar] [CrossRef]
- Yu, H.; Du, C.; Liu, H.; Wei, J.; Zhou, Z.; Huang, Q.; Yao, X. Preparation and characterization of bamboo strips impregnation treated by silver-loaded thermo-sensitive nanogels. Bioresources 2017, 12, 8390–8401. [Google Scholar] [CrossRef]
- Wang, D.; Hu, C.; Gu, J.; Tu, D.; Wang, G.; Jiang, M.; Zhang, W. Bamboo surface coated with polymethylsilsesquioxane/Cu-containing nanoparticles (PMS/CuNP) xerogel for superhydrophobic and anti-mildew performance. J. Wood Sci. 2020, 66, 33. [Google Scholar] [CrossRef]
- Lou, Z.; Han, X.; Liu, J.; Ma, Q.; Yan, H.; Yuan, C.; Yang, L.; Han, H.; Weng, F.; Li, Y. Nano-Fe3O4/bamboo bundles/phenolic resin-oriented recombination ternary composite with enhanced multiple functions. Compos. B Eng. 2021, 226, 109335. [Google Scholar] [CrossRef]
- Li, J.; Wu, Z.; Bao, Y.; Chen, Y.; Huang, C.; Li, N.; He, S.; Chen, Z. Wet chemical synthesis of ZnO nanocoating on the surface of bamboo timber with improved mould-resistance. J. Saudi Chem. Soc. 2017, 21, 920–928. [Google Scholar] [CrossRef]
- Chen, J.; Ma, Y.; Lin, H.; Zheng, Q.; Zhang, X.; Yang, W.; Li, R. Fabrication of hydrophobic ZnO/PMHS coatings on bamboo surfaces: The synergistic effect of ZnO and PMHS on anti-mildew properties. Coatings 2018, 9, 15. [Google Scholar] [CrossRef]
- Ren, D.; Li, J.; Xu, J.; Wu, Z.; Bao, Y.; Li, N.; Chen, Y. Efficient antifungal and flame-retardant properties of ZnO-TiO2-layered double-nanostructures coated on bamboo substrate. Coatings 2018, 8, 341. [Google Scholar] [CrossRef]
- Pandoli, O.; Martins, R.D.S.; Romani, E.C.; Paciornik, S.; Maurício, M.H.D.P.; Alves, H.D.L.; Pereira-Meirelles, F.V.; Luz, E.L.; Koller, S.M.L.; Valiente, H.; et al. Colloidal silver nanoparticles: An effective nano-filler material to prevent fungal proliferation in bamboo. RSC Adv. 2016, 6, 98325–98336. [Google Scholar] [CrossRef]
- Debnath, S.; Karmakar, P.; Bhattacharjee, S.; Majumdar, K.; Das, P.; Saha, A.K. Isolation and identification of fungal assemblages in the necrotic spots of Bambusa pallida (L.) Voss. Annu. Plant Sci. 2018, 7, 2160–2165. [Google Scholar] [CrossRef][Green Version]
- Kim, J.J.; Lee, S.S.; Ra, J.B.; Lee, H.; Huh, N.; Kim, G.H. Fungi associated with bamboo and their decay capabilities. Holzforschung 2011, 65, 271–275. [Google Scholar] [CrossRef]
- Gardes, M.; Bruns, T.D. ITS primers with enhanced specificity for basidiomycetes-application to the identification of mycorrhizae and rusts. Mol. Ecol. 1993, 2, 113–118. [Google Scholar] [CrossRef] [PubMed]
- Morakotkarn, D.; Kawasaki, H.; Seki, T. Molecular diversityof bamboo-associated fungi isolated from Japan. FEMS Microbiol. Lett. 2007, 266, 10–19. [Google Scholar] [CrossRef] [PubMed]
- Hummers Jr, W.S.; Offeman, R.E. Preparation of graphitic oxide. J. Am. Chem. Soc. 1958, 80, 1339. [Google Scholar] [CrossRef]
- Sun, F.; Bao, B.; Ma, L.; Chen, A.; Duan, X. Mould-resistance of bamboo treated with the compound of chitosan-copper complex and organic fungicides. J. Wood Sci. 2012, 58, 51–56. [Google Scholar] [CrossRef]
- Yang, H.; Deng, Y. Preparation and physical properties of superhydrophobic papers. J. Colloid Interface Sci. 2008, 325, 588–593. [Google Scholar] [CrossRef]
- Jin, C.; Li, J.; Han, S.; Wang, J.; Sun, Q. A durable, superhydrophobic, superoleophobic and corrosion-resistant coating with rose-like ZnO nanoflowers on a bamboo surface. Appl. Surf. Sci. 2014, 320, 322–327. [Google Scholar] [CrossRef]
- Li, J.; Sun, Q.; Yao, Q.; Wang, J.; Han, S.; Jin, C. Fabrication of robust superhydrophobic bamboo based on ZnO nanosheet networks with improved water-, UV-, and fire-resistant properties. J. Nanomater. 2015, 2015, 431426. [Google Scholar] [CrossRef]
- ASTM D2017-05; Standard Method of Accelerated Laboratory Test of Natural Decay Resistance of Wood. American Society for Testing and Materials: West Conshohocken, PA, USA, 2008.
- Cloutier, M.; Mantovani, D.; Rosei, F. Antibacterial coatings: Challenges, perspectives, and opportunities. Trends Biotechnol. 2015, 33, 637–652. [Google Scholar] [CrossRef] [PubMed]
- Wei, D.; Schmidt, O.; Liese, W. Method to test fungal degradation of bamboo and wood using vermiculite as reservoir for moisture and nutrients. Maderas-Cienc. Tecnol. 2013, 15, 349–356. [Google Scholar] [CrossRef]
- Kordali, S.; Cakir, A.; Ozer, H.; Cakmakci, R.; Kesdek, M.; Mete, E. Antifungal, phytotoxic and insecticidal properties of essential oil isolated from Turkish Origanum acutidens and its three components, carvacrol, thymol and p-cymene. Bioresour. Technol. 2008, 99, 8788–8795. [Google Scholar] [CrossRef] [PubMed]
- Sun, Q.; Yu, H.; Liu, Y.; Li, J.; Cui, Y.; Lu, Y. Prolonging the combustion duration of wood by TiO2 coating synthesized using cosolvent-controlled hydrothermal method. J. Mater. Sci. 2010, 45, 6661–6667. [Google Scholar] [CrossRef]
- Desai, R.; Mankad, V.; Gupta, S.K.; Jha, P.K. Size distribution of silver nanoparticles: UV-visible spectroscopic assessment. Nanosci. Nanotechnol. Lett. 2012, 4, 30–34. [Google Scholar] [CrossRef]
- Andersson, S.; Serimaa, R.; Paakkari, T.; Saranpaa, P.; Pesonen, E. Crystallinity of wood and the size of cellulose crystallites in Norway spruce (Picea abies). J. Wood Sci. 2003, 49, 531–537. [Google Scholar] [CrossRef]
- Li, J.; Zheng, H.; Sun, Q.; Han, S.; Fan, B.; Yao, Q.; Yan, C.; Jin, C. Fabrication of superhydrophobic bamboo timber based on an anatase TiO2 film for acid rain protection and flame retardancy. RSC Adv. 2015, 5, 62265–62272. [Google Scholar] [CrossRef]
- Wang, G.; Yang, J.; Park, J.; Gou, X.; Wang, B.; Liu, H.; Yao, J. Facile synthesis and characterization of graphene nanosheets. J. Phys. Chem. C 2008, 112, 8192–8195. [Google Scholar] [CrossRef]
- Caccia, M.; Giuranno, D.; Molina-Jorda, J.M.; Moral, M.; Nowak, R.; Ricci, E.; Sobczak, N.; Narciso, J.; Fernández Sanz, J. Graphene translucency and interfacial interactions in the Gold/Graphene/SiC system. J. Phys. Chem. 2018, 9, 3850–3855. [Google Scholar] [CrossRef]
- Dinh, D.A.; Hui, K.S.; Hui, K.N.; Cho, Y.R.; Zhou, W.; Hong, X.; Chun, H.H. Green synthesis of high conductivity silver nanoparticle-reduced graphene oxide composite films. Appl. Surf. Sci. 2014, 298, 62–67. [Google Scholar] [CrossRef]
- Chen, J.; Zheng, X.; Wang, H.; Zheng, W. Graphene oxide-Ag nanocomposite: In situ photochemical synthesis and application as a surface-enhanced Raman scattering substrate. Thin Solid Films 2011, 520, 179–185. [Google Scholar] [CrossRef]
- ISO 13061-1; Physical and Mechanical Properties of Wood—Test Methods for Small Clear Wood Specimens—Part 1: Determination of Moisture Content for Physical and Mechanical Tests. International Organization for Standardization: Geneva, Switzerland, 2014.
- Lu, Y.; Xiao, S.; Gao, R.; Li, J.; Sun, Q. Improved weathering performance and wettability of wood protected by CeO2 coating deposited onto the surface. Holzforschung 2014, 68, 345–351. [Google Scholar] [CrossRef]
- Peng, Y.; Wu, S. The structural and thermal characteristics of wheat straw hemicellulose. J. Anal. Appl. Pyrolysis 2010, 88, 134–139. [Google Scholar] [CrossRef]
- Akhavan, O.; Ghaderi, E. Toxicity of graphene and graphene oxide nanowalls against bacteria. ACS Nano 2010, 4, 5731–5736. [Google Scholar] [CrossRef] [PubMed]
- Chen, J.; Peng, H.; Wang, X.; Shao, F.; Yuan, Z.; Han, H. Graphene oxide exhibits broad-spectrum antimicrobial activity against bacterial phytopathogens and fungal conidia by intertwining and membrane perturbation. Nanoscale 2014, 6, 1879–1889. [Google Scholar] [CrossRef]

| Nanomaterials | Process | Effect | Ref. |
|---|---|---|---|
| rGO | Ultrasonic dispersion and hydrothermal reduction | Improved bamboo decay resistance | Wang et al. [27] |
| GO-SiO2 | SiO2 sprayed on GO-bamboo | Improved hydrophobicity and dimensional stability | Wang et al. [31] |
| Fe-doped TiO2 films | Deposited using the co-precipitation method on bamboo surface and doping carried via the immersion of bamboo in nano suspension | Improved antifungal activity | Li et al. [32] |
| Ag/TiO2 | Ag and TiO2 nanoparticles being immobilized on the surface of polydopamine-bamboo composite via impregnation-adsorption and in situ growth | Anti-mildew property | Liu et al. [33] |
| Ag/TiO2 | Hydrothermal immobilization of TiO2 on bamboo and AgNPs embedded on TiO2 films | Superior antifungal activity and complete inhibition of T. viride and P. citrinum | Li et al. [34] |
| Ag nanogel | Impregnation treatment | Long-term antifungal effect; mildew resistance against A. niger | Yu et al. [35] |
| PMS/CuNP | Bamboo immersed in alkaline SMS and acidic CuCl2 solution and dried at 103° for 2 h | Increased hydrophobicity, with an anti-mildew effect | Wang et al. [36] |
| Fe3O4 | Co-precipitation and deposition | Improved hydrophobic properties, with a water contact angle of 116.8° | Lou et al. [37] |
| ZnO | Colloidal deposition of ZnO and wet chemical treatment | Resistant against A. niger and P. citrinum; weaker resistance against T. viride | Li et al. [38] |
| ZnO/PMHS | Dip dry and hydrothermal treatment | Synergistic antifungal activity by ZnO and PMHS | Chen et al. [39] |
| ZnO-TiO2 | Liquid phase deposition | Improved thermal stability, with a flame-retardant property | Ren et al. [40] |
| AgNPs | Impregnation of bamboo in AgNPs colloidal solution | Inhibition of fungal proliferation | Pandoli et al. [41] |
Publisher’s Note: MDPI stays neutral with regard to jurisdictional claims in published maps and institutional affiliations. |
© 2022 by the authors. Licensee MDPI, Basel, Switzerland. This article is an open access article distributed under the terms and conditions of the Creative Commons Attribution (CC BY) license (https://creativecommons.org/licenses/by/4.0/).
Share and Cite
Balakrishnan, D.; Lee, C.-I. Surface Functionalization of Bamboo with Silver-Reduced Graphene Oxide Nanosheets to Improve Hydrophobicity and Mold Resistance. Coatings 2022, 12, 980. https://doi.org/10.3390/coatings12070980
Balakrishnan D, Lee C-I. Surface Functionalization of Bamboo with Silver-Reduced Graphene Oxide Nanosheets to Improve Hydrophobicity and Mold Resistance. Coatings. 2022; 12(7):980. https://doi.org/10.3390/coatings12070980
Chicago/Turabian StyleBalakrishnan, Dhivyabharathi, and Cheng-I Lee. 2022. "Surface Functionalization of Bamboo with Silver-Reduced Graphene Oxide Nanosheets to Improve Hydrophobicity and Mold Resistance" Coatings 12, no. 7: 980. https://doi.org/10.3390/coatings12070980
APA StyleBalakrishnan, D., & Lee, C.-I. (2022). Surface Functionalization of Bamboo with Silver-Reduced Graphene Oxide Nanosheets to Improve Hydrophobicity and Mold Resistance. Coatings, 12(7), 980. https://doi.org/10.3390/coatings12070980

